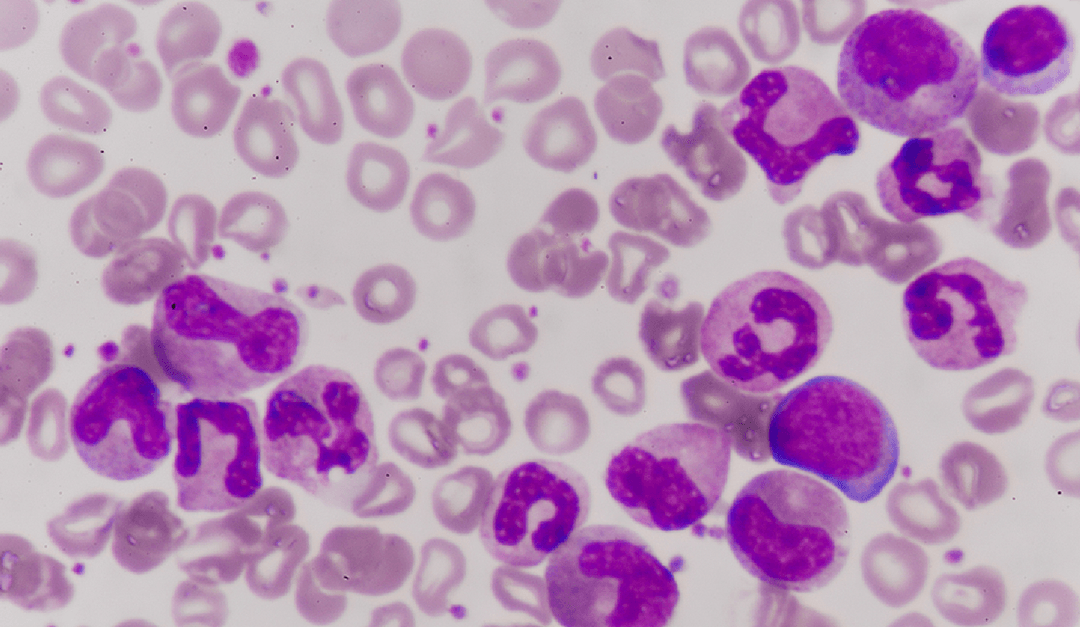
Odkryto rzadkie komórki, które mogą przemienić się w białaczkę. Mamy je wszyscy

#medycyna
505 artykułówTag: #medycyna
Przychodzi mumia do lekarza. Na co umierali starożytni?
Niewydolność serca, miażdżyca czy nowotwory to nie choroby cywilizacyjne! Udowodnili to naukowcy badający… starożytne mumie Choć Nebiri, egipski zarządca staj-ni, nie żyje już od 3,5 tysiąca lat, stan jego zdrowia stanowi przedmiot wielkiej troski współczesnych badaczy. „Mamy dowody na istnienie zwapnień w jego wewnętrznej tętnicy szyjnej” – obwieściła niedawno na specjalnie zwołanej konferencji prasowej dr Raffaella […]
Nie pytaj tych osób o wspomnienia z wakacji. U nich wyobraźnia działa inaczej
Stwierdzenie „widzę to oczyma wyobraźni” jest dla osób cierpiących na afantazję abstrakcyjne i niezrozumiałe. Od kiedy pamiętają, nie potrafili przywołać w myślach żadnego obrazu Zamknij oczy i wyobraź sobie, że siedzisz na piaszczystej nadmorskiej plaży i podziwiasz piękny zachód słońca. Spróbuj wydobyć z pamięci wszystkie kształty i kolory: świetlistą kulę czerwieniejącą nad horyzontem, różowe i fioletowe pasma chmur, ciemną taflę […]
Niedotlenienie krzepi. Niedobór tlenu może poprawić kondycję i pomóc w odchudzaniu
Ewolucja przygotowała nas, byśmy jak najdłużej przeżyli w powietrzu zawierającym ok. 21 proc. tlenu przy ciśnieniu jednej atmosfery. Wyposażyła nas też w mechanizmy, które chronią organizm przed zbyt małą lub zbyt dużą ilością tego gazu. Nowoczesna medycyna coraz sprawniej te przystosowania wykorzystuje. Badania przeprowadzone w armii amerykańskiej sugerują, że wybawieniem dla osoby ze skłonnością do […]
Szczepionkowe nadzieje. Czy dzięki szczepieniom pokonamy w końcu choroby zakaźne?
Pandemia COVID-19 uświadomiła znaczenie szczepionek w ochronie zdrowia. Przedtem nie interesowano się nimi niemal wcale. Czy dzięki nowym szybkim technologiom uda się uwolnić świat od chorób zakaźnych? Pandemia COVID-19 uruchomiła potężny strumień pieniędzy na badania nad szczepionkami, które byłyby w stanie przerwać tragiczną lawinę zakażeń. To dofinansowanie, na niespotykaną w historii skalę, ze strony rządu […]
Wojna z przerzutami raka. 5 nowych sposobów na pokonanie nowotworu
Aż u 90 proc. chorych na nowotwory przyczyną zgonu jest rozwój przerzutu. Na szczęście naukowcy znajdują nowe sposoby na powstrzymanie raka przed rozsianiem się po organizmie. Wiele typów nowotworów zdiagnozowanych we wczesnym stadium udaje się całkowicie wyleczyć. Ale gdy dochodzi do przerzutów, które atakują odległe narządy – etap choroby określany przez lekarzy jako stadium IV […]